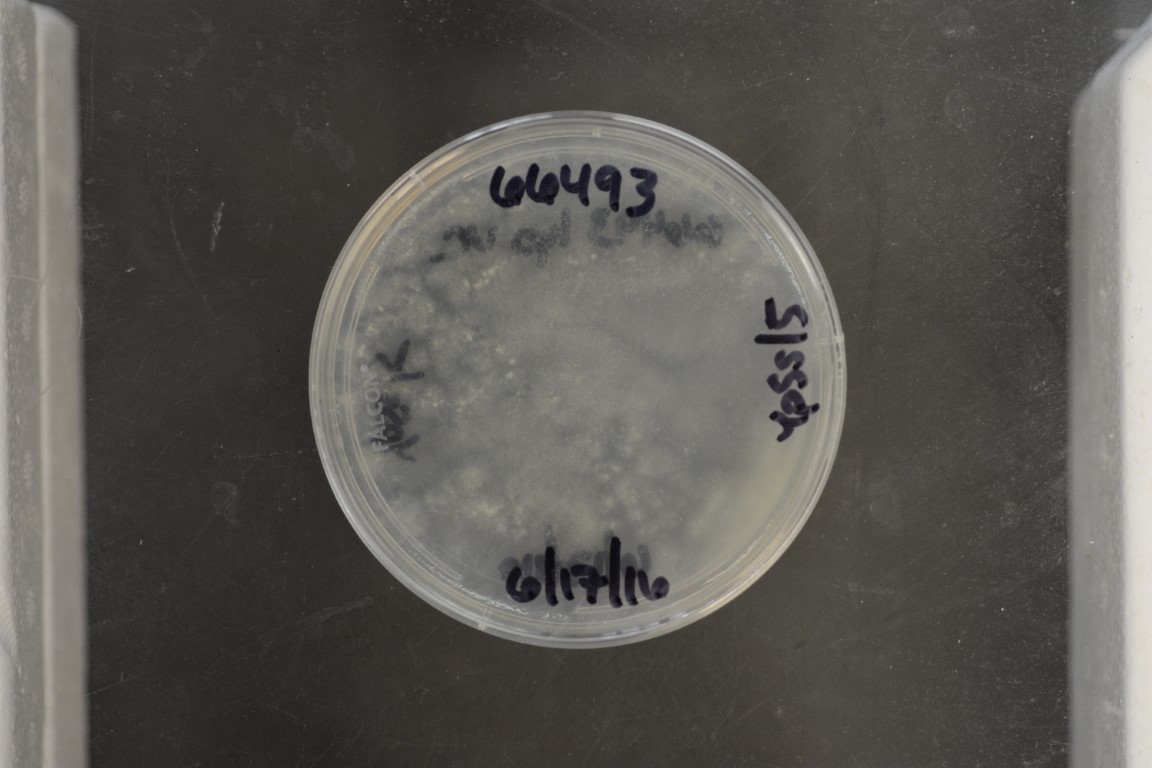

Syncephalis plumigaleata
NRRL 66493
Accession numbers in other collections:S24
Source:Nicole Reynolds,Plant Pathology,University of Florida,Gaineville Fl 32611
Isolated from(substrate):Soil coll 13 June 2003 by GL.Benny under a large Ginko tree
Substrate location:Massachusetts.Hampshire County,Northampton,Smith College,,U.S.A.
Growth media:YpSs/5(number 38)
Optimum growth temperature:25C
Strain images:
NRRL_66493_38.JPG

Comments:Host:Zygorhynchus moelleri
NRRL66493